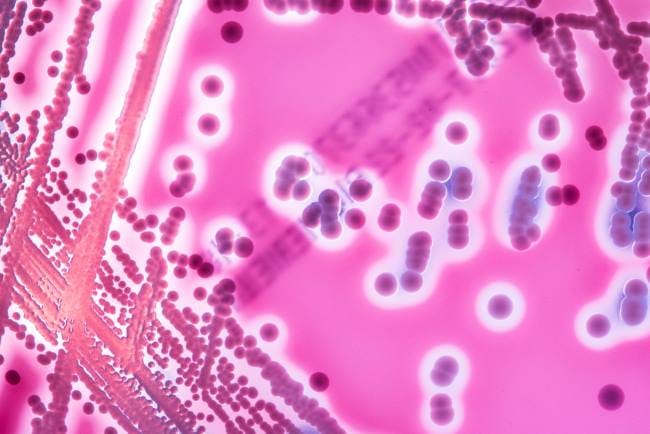
Streptococcus, Bakteri Penyebab Infeksi yang Perlu Diwaspadai - Alodokter

Streptococcus adalah bakteri yang sering menjadi penyebab infeksi, seperti radang tenggorokan, demam scarlet, atau bahkan infeksi kulit. Infeksi ini bisa menimbulkan gejala yang beragam, mulai dari gejala yang tidak mengganggu aktivitas sampai yang dapat membahayakan nyawa.
Streptococcus pada dasarnya dapat hidup dan tumbuh di tubuh manusia tanpa menimbulkan penyakit yang serius. Namun, beberapa tipe bakteri Streptococcus bisa menyebabkan infeksi.
Streptococcus terbagi menjadi dua, yaitu infeksi Streptococcus tipe A dan Streptococcus tipe B. Infeksi Streptococcus tipe A umumnya menyerang tenggorokan dan kulit, menyebabkan demam scarlet, radang tenggorokan, demam rematik, impetigo, dan glomerulonefritis.
Sementara itu, Streptococcus tipe B paling sering menyebabkan sepsis, pneumonia, dan meningitis pada bayi. Pada orang dewasa, Streptococcus tipe B mengakibatkan infeksi saluran kemih, infeksi kulit, infeksi jaringan lunak (selulitis), sepsis, infeksi tulang dan sendi, serta pneumonia.
Streptococcus dan Gejala yang Ditimbulkannya
Infeksi Streptococcus di tenggorokan biasanya menimbulkan gejala yang cukup khas. Berikut ini adalah tanda-tanda yang perlu Anda perhatikan:
- Sakit tenggorokan yang muncul mendadak
- Demam, biasanya lebih dari 38°C
- Pembengkakan dan kemerahan pada amandel, kadang terdapat bercak putih
- Sulit atau nyeri saat menelan
- Pembesaran kelenjar getah bening di leher
- Sakit kepala, mual, atau muntah (lebih sering terjadi pada anak-anak)
Selain itu, infeksi Streptococcus juga dapat menyebabkan ruam merah pada kulit (demam scarlet), napas berbau tidak sedap, atau badan terasa sangat lemah.
Streptococcus dan Cara Penularannya
Infeksi Streptococcus memiliki penyebab serta pola penularan yang berbeda, tergantung pada jenisnya. Bakteri Streptococcus tipe A dapat hidup di kulit dan tenggorokan manusia. Penularan bakteri ini bisa terjadi akibat:
- Melakukan kontak langsung, misalnya dengan bersentuhan atau berciuman, dengan orang yang terinfeksi atau membawa bakteri Streptococcus tipe A
- Menghirup percikan air liur orang yang terinfeksi atau membawa bakteri Streptococcus tipe A
- Menggunakan alat makan atau mengonsumsi makanan yang terkontaminasi
Sementara itu, Streptococcus tipe B bisa hidup di usus, vagina, ataupun area dubur. Meski umumnya tidak berbahaya, bakteri ini tetap dapat menyebabkan infeksi dalam kondisi tertentu.
Pola penyebaran bakteri ini belum sepenuhnya dipahami, tetapi diketahui bahwa Streptococcus tipe B tidak menyebar melalui makanan, air, ataupun hubungan seksual.
Kini, Anda sudah mengetahui penularan bakteri Streptococcus berdasarkan jenisnya. Oleh karena itu, penting bagi Anda untuk melakukan pencegahan agar terhindar dari infeksi Streptococcus di kemudian hari.
Berikut ini adalah beberapa langkah pencegahan yang dapat dilakukan:
- Mencuci tangan dengan sabun, terutama setelah batuk, bersin, atau sebelum makan
- Tidak berbagi alat makan, minum, atau handuk dengan orang yang sedang sakit tenggorokan
- Mengajarkan etika batuk dan bersin, yaitu dengan menutup mulut menggunakan tisu atau siku, bukan dengan tangan
- Mengisolasi sementara anggota keluarga yang sakit agar tidak menularkan ke orang lain
- Membersihkan benda-benda yang sering disentuh bersama, seperti mainan atau remote TV, secara rutin
Saat ini, belum tersedia vaksin khusus untuk mencegah infeksi Streptococcus. Oleh sebab itu, perilaku hidup bersih dan peka terhadap gejala sangat penting untuk mencegah penularan.
Infeksi Streptococcus memang sering dianggap ringan, tetapi komplikasi, seperti demam rematik dan infeksi ginjal, tetap dapat terjadi jika pengobatan antibiotik tidak tuntas atau penanganan terlambat.
Jika Anda mengalami keluhan yang dicurigai akibat infeksi Streptococcus, seperti demam, sakit tenggorokan yang parah, atau keluhan lain yang tidak kunjung membaik, segera Chat Bersama Dokter di aplikasi ALODOKTER. Penanganan dini sangat penting untuk mencegah komplikasi yang lebih berat.